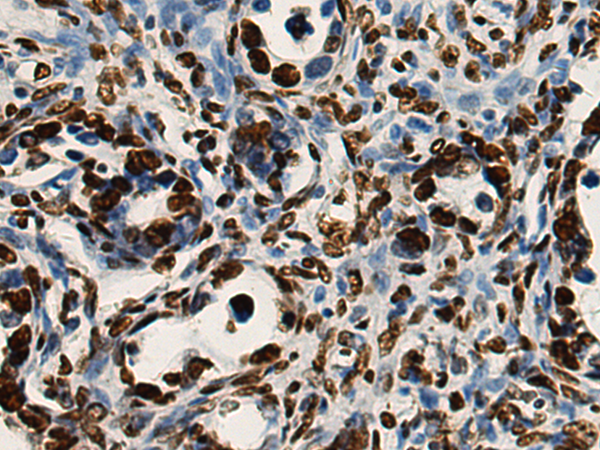
一抗

中文名稱:小鼠抗H3C1單克隆抗體
|
Background: |
Histones are basic nuclear proteins that are responsible for the nucleosome structure of the chromosomal fiber in eukaryotes. This structure consists of approximately 146 bp of DNA wrapped around a nucleosome, an octamer composed of pairs of each of the four core histones (H2A, H2B, H3, and H4). The chromatin fiber is further compacted through the interaction of a linker histone, H1, with the DNA between the nucleosomes to form higher order chromatin structures. This gene is intronless and encodes a replication-dependent histone that is a member of the histone H3 family. Transcripts from this gene lack polyA tails; instead, they contain a palindromic termination element. This gene is found in the large histone gene cluster on chromosome 6p22-p21.3. |
|
Applications: |
WB, IHC |
|
Name of antibody: |
H3C1 |
|
Immunogen: |
Fusion protein of human H3C1 |
|
Full name: |
H3 clustered histone 1 |
|
Synonyms: |
H3/A; H3C2; H3C3; H3C4; H3C6; H3C7; H3C8; H3FA; H3C10; H3C11; H3C12; HIST1H3A |
|
SwissProt: |
P68431 |
|
IHC positive control: |
Human ovarian cancer and Human breast cancer; Human gastric cancer and Human thyroid cancer |
|
IHC Recommend dilution: |
500-1000 |
|
WB Predicted band size: |
15 kDa |
|
WB Positive control: |
Human left lung tissue lysate, Jurkat, 293T, K562, NIH/3T3, Hela and 231 cell lysates |
|
WB Recommended dilution: |
10000-50000 |





 購物車
購物車 幫助
幫助
 021-54845833/15800441009
021-54845833/15800441009